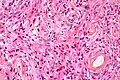
Менинготелиоматозная эпендимома

Менингиома
| Менингиома | |
|---|---|
 Компьютерная томограмма с контрастным усилением, демонстрирующая интенсивно накапливающую контрастный препарат менингиому | |
| МКБ-11 | XH11P5 |
| МКБ-10 | C70, D32 |
| МКБ-10-КМ | D32.9 |
| МКБ-9 | 225.2 |
| МКБ-9-КМ | 239.7[1] |
| МКБ-О | M9530/0 |
| OMIM | 607174 |
| DiseasesDB | 8008 |
| eMedicine | neuro/209 radio/439 |
| MeSH | D008579 |
Менингио́ма (арахноидэндотелио́ма) — опухоль, растущая из клеток паутинной мозговой оболочки, а именно арахноидального эндотелия — ткани, окружающей мозг. Вопреки распространённому убеждению, не является опухолью твёрдой мозговой оболочки. Сам термин и анатомическая классификация, используемые и ныне, введены американским нейрохирургом Кушингом в 1922 году.[2]
Патологическая анатомия

Макроскопически опухоль в большинстве случаев представляет собой хорошо отграниченный узел округлой или подковообразной формы, нередко спаянный с твёрдой мозговой оболочкой. Встречаются и плоские узлы. По величине варьируют от нескольких миллиметров до 15 см и более в диаметре. Консистенция менингиом плотная. В большинстве случаев опухоль окружена плотной капсулой. На разрезе ткань менингиомы серо-жёлтая. Цвет может варьировать. Наличие кист не характерно[3].
Гистологическая классификация
Существует несколько классификаций опухолей центральной нервной системы. Они периодически обновляются, что создаёт определённую терминологическую путаницу[4]. Первая классификация ВОЗ опухолей нервной системы была издана в 1979 году в Женеве[5]. В 1993 году появилось второе издание[6], а в 2000-м и 2007-м — третье и четвёртое, соответственно[4].
| Четвёртое издание гистологической классификации опухолей ВОЗ 2007 года | ||
|---|---|---|
| Код МКБ-О | Степень злокачественности (G=1) | |
Типическая менингиома
|
* 9530/0
|
G = I |
| Атипическая менингиома | 9539/1 | G = II |
| Хордоидная менингиома | 9538/1 | G = II |
| Светлоклеточная менингиома | 9538/1 | G = II |
| Анапластическая менингиома | 9530/3 | G = III |
| Рабдоидная менингиома | 9538/3 | G = III |
| Папиллярная менингиома | 9538/3 | G = III |
Менинготелиоматозная менингиома состоит из мозаикоподобно расположенных клеток с овальным или округлым ядром, которые содержат умеренное количество хроматина. Строма опухоли представлена немногочисленными сосудами и тонкими тяжами соединительной ткани, которые окаймляют клеточные поля. Характерны концентрические структуры из наслаивающихся одна на другую уплощённых опухолевых клеток. Центр новообразования часто обызвествлён[3].
Фиброзная менингиома состоит из фибробластоподобных клеток, которые располагаются параллельно друг другу и складываются в переплетающиеся между собой пучки, содержащие соединительнотканные волокна. Ядра вытянутые. Могут встречаться концентрические структуры и псаммомные тельца[3].
Переходная менингиома включает элементы менинготелиоматозной и фиброзной менингиом[3].
Псаммоматозная менингиома содержит большое количество псаммомных телец[3].
Ангиоматозная менингиома обильно васкуляризирована, содержит большое количество кровеносных сосудов[7].
Микрокистозная менингиома содержит большое количество микрокист, окружённых опухолевыми клетками звёздчатой формы[8].
Секреторная менингиома является редким гистологическим вариантом данного новообразования. Для неё характерна секреция веществ, которые формируют гиалиновые включения[9].
Менингиомы с обилием лимфоцитов по определению содержат большое количество включений лимфоцитарных масс.
Для метапластических менингиом характерна метаплазия (трансформирование) менинготелиальных клеток в клетки другого типа (к примеру, адипоциты)[10].
-
Менинготелиоматозная эпендимома
Менинготелиоматозная эпендимома -
 Фиброзная менингиома
Фиброзная менингиома -
_transitional_type.jpg) Переходная менингиома
Переходная менингиома -
 Ангиоматозная менингиома
Ангиоматозная менингиома -
 Секреторная менингиома
Секреторная менингиома -
 Папиллярная менингиома
Папиллярная менингиома -
 Анапластическая менингиома
Анапластическая менингиома -
 Атипическая менингиома
Атипическая менингиома -
 Хордоидная менингиома
Хордоидная менингиома -
 Микрокистозная менингиома
Микрокистозная менингиома
В подавляющем большинстве случаев менингиома — это доброкачественное новообразование, однако возможны и злокачественные варианты. Согласно существующей классификации ВОЗ в зависимости от гистологической картины существует три типа менингиом[11]:
- Grade-1 (1-я степень злокачественности): доброкачественные, медленно растущие образования, без атипии, не инфильтрирующие окружающие ткани. Характеризуются благоприятным прогнозом и низкой частотой рецидивирования. Включает 9 подтипов. Составляет 94,5 % от всех менингиом.
- Grade-2 (2-я степень злокачественности): атипичные, характеризующиеся более агрессивным, быстрым ростом, более высокой частотой рецидивирования и менее благоприятным прогнозом. Включает 3 подтипа. Составляет 4,7 % от всех менингиом.
- Grade-3 (3-я степень злокачественности): злокачественные новообразования с неблагоприятным прогнозом, высокой частотой рецидивирования, агрессивно растущие и вовлекающие окружающие ткани в процесс. Включает 3 подтипа. В среднем 1 % всех менингиом. Чаще встречается у мужчин[11].
Эпидемиология
Составляют 13—25 % от всех первичных внутричерепных новообразований.[12] Средняя распространённость симптоматических менингиом (имеющих клинические проявления) в популяции составляет 2,0/100 000 населения. В то же время распространённость асимптоматических (бессимптомных) менингиом составляет 5,7/100 000 населения[13]. Асимптоматические менингиомы являются находкой 1—2,3 % всех аутопсий[14]
Менингиомы чаще встречаются у женщин. Соотношение мужчины:женщины в группе пациентов с менингиомами составляет от 1:1,4 до 1:2,6[15][16].
Локализация

Наиболее часто внутричерепные менингиомы располагаются парасагиттально и на фальксе (25 %). Конвекситально — в 19 % случаев. На крыльях основной кости — 17 %. Супраселлярно — 9 %. Задняя черепная ямка — 8 %. Ольфакторная ямка — 8 %. Средняя черепная ямка — 4 %. Намет мозжечка — 3 %. В боковых желудочках, большом затылочном отверстии и зрительном нерве — по 2 %.[17] Поскольку паутинная мозговая оболочка покрывает и спинной мозг, то возможно и развитие так называемых спинальных менингиом. Данный вид новообразований является самой частой интрадуральной экстрамедуллярной опухолью спинного мозга у человека[18].
Клинические проявления
Специфической неврологической симптоматики у менингиом нет. Зачастую заболевание может протекать бессимптомно годами, а первым его проявлением в большинстве случаев становится головная боль. Она также не носит специфического характера и чаще всего представляется больному как тупая, ноющая, распирающая, разлитая боль в лобно-височной области с двух сторон в ночные и утренние часы.
Симптомы заболевания зависят от расположения опухоли и могут выражаться следующим образом:
- слабость в конечностях (парез);
- снижение остроты зрения и выпадение полей зрения;
- появление двоения в глазах и опущение века;
- нарушение чувствительности в различных участках тела;
- эпилептические приступы;
- появление психоэмоциональных расстройств;
- просто головные боли.
Запущенные стадии заболевания, когда менингиома, достигая больших размеров, вызывает отёк и сдавление мозговой ткани, что приводит к резкому повышению внутричерепного давления, проявляются обычно сильными головными болями с тошнотой, рвотой, угнетением сознания и реальной угрозой для жизни пациента.
Диагностика
Для диагностики менингиом используются следующие методы нейровизуализации: МРТ, КТ, ПЭТ, селективная и неселективная церебральная ангиография, сцинтиграфия.
МРТ

В настоящее время МРТ с контрастным усилением является ведущим методом диагностики менингиом практически любой локализации. МРТ позволяет визуализировать васкуляризацию опухоли, степень поражения артерий и венозных синусов, а также взаимоотношения между опухолью и окружающими структурами. На нативных T1-взвешенных МРТ большинство менингиом не отличаются по интенсивности от коры головного мозга. Фиброматозные менингиомы могут быть по интенсивности и ниже коры. На T2-взвешенных МРТ менингиомы обычно повышенной интенсивности, отёк также хорошо виден на T2-взвешенных МРТ. Интенсивное контрастное усиление выявляется у 85 % менингиом. У менингиом часто встречается так называемый «дуральный хвост», участок прилежащей ТМО, интенсивно накапливающий КВ. Эта ТМО может быть как опухолево, так и реактивно изменённой. «Дуральный хвост» встречается у 65 % менингиом и только у 15 % других опухолей. Поэтому он хотя и не специфичен для менингиомы, но позволяет более точно высказаться в её пользу. Среди недостатков этого метода необходимо отметить высокую частоту ложноотрицательных результатов в отношении диагностики наличия кальцинатов и очагов кровоизлияний.
КТ
КТ с контрастированием сопровождается умеренным-выраженным гомогенным усилением в большинстве случаев. При помощи КТ диагностируются около 90 % менингиом. Главная роль КТ — демонстрация изменения костей и кальцинатов в опухоли.
ПЭТ
Ввиду высокой себестоимости метода и относительно низкой специфичности, в диагностике менингиом широкого распространения не получил.
Ангиография
Позволяет визуализировать кровоснабжение опухоли. С учётом инвазивности и лучевой нагрузки, значение в основном вспомогательное. Однако в сочетании с селективной эмболизацией сосудов опухоли может быть использован как метод предоперационной подготовки, а в ряде случаев и как самостоятельный метод лечения.
Лечение

Большинство менингиом имеют доброкачественный характер, и основным методом их лечения является хирургическое удаление.
Тяжесть хирургической операции и её исход, в основном, определяются расположением опухоли — её близостью к функционально значимым отделам мозга и соотношением с анатомическими структурами — сосудами и нервами.
В большинстве случаев радикальное удаление менингиомы обеспечивает фактически «излечение» или снижает риск повторного образования опухоли (рецидива) практически до нуля. Небольшая категория менингиом, имеющих недоброкачественный характер, склонна к быстрому рецидивированию, что требует повторных операций.
Помимо хирургического, другие методы в лечении менингиом используются относительно редко.
Обычная, ротационная гамма-терапия (лучевая терапия, облучение) малоэффективна в лечении большинства вариантов менингиом. Стереотаксические методики облучения применяются, в первую очередь, для лечения опухолей, расположенных в труднодоступных для хирургического удаления или в функционально значимых зонах. Стереотаксическая радиохирургия применима для лечения опухолей сравнительно небольшого размера (до 3,5 см в диаметре). Стереотаксическая радиотерапия применима также и для опухолей большего размера. Часто стереотаксическое облучение используется в сочетании с хирургическим лечением (в основном после операции для снижения риска рецидива, облучения части опухоли, которая не могла быть удалена при хирургической операции).
Химиотерапия в лечении доброкачественных менингиом не применяется.
Прогноз
Зависит от локализации, распространённости процесса и гистологического типа менингиомы. Доброкачественные менингиомы (без атипии, grade-1), будучи хирургически тотально удалены, не рецидивируют и не требуют дальнейшего лечения. Однако тотальное удаление даже доброкачественных менингиом в ряде случаев (менингиомы фалькс-тенториального угла, петрокливальные, кавернозного синуса, основания черепа, множественные) является затруднительным.
по локализации
Так, согласно исследованиям, конвекситальные менингиомы (свода черепа) после полного удаления имеют 3 % вероятность рецидивирования в течение последующих пяти лет. Для параселлярных этот показатель выше — 19 %, тела основной кости — 34 %.[19] Наиболее же высоким 5-летним индексом рецидивирования обладают менингиомы крыльев основной кости с вовлечением кавернозного синуса — 60–100 %[20].
по гистологии
Немаловажное значение в отношении прогноза имеет и гистологический тип. Доброкачественные (grade-1) менингиомы имеют 3 % индекс рецидивирования в течение 5 лет после полного удаления. Для атипичных и злокачественных (grade-2 и grade-3) он равен 38 % и 78 % соответственно[21].
Литература
- Гринберг М. С. Нейрохирургия. — Москва: МЕДпресс-информ, 2010. — 1008 с. — ISBN 978-5-98322-550-3.
- Joung H. Lee. Meningiomas. — Springer, 2008. — 639 p. — ISBN 978-1-84628-526-4.
Примечания
- ↑ Monarch Disease Ontology release 2018-06-29 — 2018-06-29 — 2018.
- ↑ Cushing H. The meningiomas (dural endotheliomas): their source and favored seats of origin (Cavendish Lecture). Brain. 1922;45:282–316.
- ↑ 1 2 3 4 5 Архангельский В. В., Бродская И. А. Менингиома // Большая медицинская энциклопедия / под общей редакцией Б. В. Петровского. — 3-е издание. — М.: «Советская энциклопедия», 1981. — Т. 15 (Меланома — Мудров). — С. 26—27. — 576 с. — 150 000 экз.
- ↑ 1 2 Батороев Ю. К. О новых нозологических формах ВОЗ-классификации опухолей центральной нервной системы (четвёртое переиздание, 2007) (недоступная ссылка — история) // Сибирский медицинский журнал. — 2009. — № 1. — С. 5—12.
- ↑ Zülch K. J. Histological typing of the tumors of the central nervous system. International classification of tumors. — World Health Organization. — Geneva, 1979.
- ↑ Kleihues P., Burger P. C., Scheithauer B. W. Histological typing of the tumors of the central nervous system. International classification of tumors. 2nd ed.. — World Health Organization. — Berlin, 1993.
- ↑ Dietzmann K., von Bossanyi P., Warich-Kirches M. et al. Immunohistochemical detection of vascular growth factors in angiomatous and atypical meningiomas, as well as hemangiopericytomas (англ.) // Pathol Res Pract. — 1997. — Vol. 193, no. 7. — P. 503—510. — doi:10.1016/S0344-0338(97)80104-5. — PMID 9342757.
- ↑ Ng H. K., Tse C. C., Lo S. T. Microcystic meningiomas--an unusual morphological variant of meningiomas (англ.) // Histopathology. — 1989. — Vol. 14, no. 1. — P. 1—9. — doi:10.1111/j.1365-2559.1989.tb02109.x. — PMID 2925174.
- ↑ Probst-Cousin S., Villagran-Lillo R., Lahl R. et al. Secretory meningioma: clinical, histologic, and immunohistochemical findings in 31 cases (англ.) // Cancer. — 1997. — Vol. 79, no. 10. — P. 2003—2015. — PMID 9149029. Архивировано 7 марта 2016 года.
- ↑ Harmouch T., Colombat M., El Amri A. et al. Lipomatous meningioma: two case reports // Ann Pathol. — 2005. — Vol. 25, № 2. — P. 389—392. — PMID 16498292.
- ↑ 1 2 Jääskeläinen J., Haltia M., Servo A. Atypical and anaplastic meningiomas: radiology, surgery, radiotherapy, and outcome // Surg Neurol. — 1986. — Vol. 25, № 3. — P. 233—242. — PMID 3945904.
- ↑ Bondy M, Ligon BL. Epidemiology and etiology of intracranial meningiomas: A review. J Neurooncol 1996;29:197–205.
- ↑ Longstreth WT Jr, Dennis LK, McGuire VM, et al. Epidemiology of intracranial meningioma. Cancer 1993;72:639–48.
- ↑ Kurland LT, Schoenberg BS, Annegers JF, et al. The incidence of primary intracranial neoplasms in Rochester, Minnesota, 1935–1977. Ann NY Acad Sci 1982;381:6–16.
- ↑ Alessandro GD, Giovanni MD, Iannizzi L, et al. Epidemiology of primary intracranial tumors in the Valle d’Aosta (Italy) during the 6-year period 1986–1991. Neuroepidemiology 1995;14: 139–46.
- ↑ Rohringer M, Sutherland GR, Louw DF, et al. Incidence and clinicopathological features of meningioma. J Neurosurg 1989;71:665–72.
- ↑ Christensen HC, Kosteljanetz M, Johansen C. Incidence of gliomas and meningiomas in Denmark, 1943 to 1997. Neurosurgery 2003;52:1327–34.
- ↑ Bret P, Lecuire J, Lapras C, et al. [Intraspinal meningiomas. A series of 60 cases]. Neurochirurgie 1976; 22:5–22.
- ↑ Mirimanoff RO, Dosoretz DE, Linggood RM, et al. Meningioma: analysis of recurrence and progression following neurosurgical resection. J Neurosurg 1985;62:18–24.
- ↑ Mathiesen T, Lindquist C, Kihlström L, et al. Recurrence of cranial base meningiomas. Neurosurgery 1996;39:2–9.
- ↑ Palma L, Celli P, Franco C, et al. Long-term prognosis for atypical and malignant meningiomas: a study of 71 surgical cases. J Neurosurg 1997;86:793–800.
Ссылки
- Клиническая презентация больной с субтенториальной менингиомой (iNeurologist)
- Клиническая презентация больной с рецидивом атипичной менингиомы (iNeurologist)